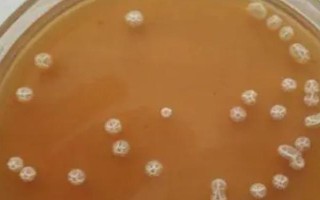
枯草芽孢杆菌的适宜温度，25-37℃为佳

锦鲤容易得什么病,可能是肤霉病或其它病菌感染导致的
锦鲤溃烂有可能是肤霉病或其他病菌感染所致。硫酸铜药浴:捞出病鱼单独饲养,并使用硫酸铜与海水混合液进行药浴,而原缸则使用杀菌剂全面消毒,最后将病鱼重新放回鱼缸。隔离消毒:将锦鲤放入老水和新水的混合水中,...
06-10
温度为10-24℃时,枯草芽孢杆菌只能缓慢生长,其生长速度会随着温度的持续上升而加快。
枯草芽孢杆菌的生长适温为25-37℃,在此条件下,它们繁殖一代仅需20-30分钟。
温度达到48℃以上时,枯草芽孢杆菌的生长速度会变缓,但繁殖仍在继续。
温度达到60℃时,枯草芽孢杆菌也能长期存活。达到120℃时,只能生存20分钟左右。

1、枯草芽孢杆菌在10-24℃的温度下,生长速度较为缓慢,但是随着温度的不断升高,生长速度会逐渐加快。
2、25-37℃为枯草芽孢杆菌的适宜生长温度,在该温度条件下,枯草芽孢杆菌每隔20-30分钟繁殖一代。
3、温度超过48℃,枯草芽孢杆菌的生长速度受到抑制,但仍然可以进行繁殖。
4、在60℃的温度下,枯草芽孢杆菌仍旧可以长时间存活,120℃的温度下,可以存活20分钟左右。
1、枯草芽孢杆菌的作用
(1)可以提高作物的抗病、抗寒、抗旱能力。
(2)可提高土壤的养分,改良土壤的结构,提高肥料利用率。
(3)能够促使土壤中的有机质分解成腐殖质,从而刺激作物的生长。
(4)可促进作物生长、成熟、降低成本、增加产量、提高收入。
(5)有一定的固氮、解磷、解钾的作用。

2、枯草芽孢杆菌的使用方式
(1)可防治稻瘟病、纹枯病、稻曲病。可在水稻孕穗破口期和齐穗期各施药一次,每亩使用枯草芽孢杆菌10克,间隔7-12天,均匀喷雾即可。

(2)枯草芽孢杆菌可以跟咪鲜胺、三环唑、井冈霉素等混用,有较好的相互增效作用。在病害集中、急性暴发时,更加能体现出混用的效果。
标签: 枯草芽孢杆菌的适宜温度
相关文章
锦鲤溃烂有可能是肤霉病或其他病菌感染所致。硫酸铜药浴:捞出病鱼单独饲养,并使用硫酸铜与海水混合液进行药浴,而原缸则使用杀菌剂全面消毒,最后将病鱼重新放回鱼缸。隔离消毒:将锦鲤放入老水和新水的混合水中,...
06-10
农业、林业、牧业、副业和渔业所需要的生产资料的总称,即为农业生产资料,它是农业生产的物质要素。发展农业、林业、牧业、副业和渔业时,为它们提供适宜的生产资料能顺利产出农产品,其中常见的农业生产资料包括塑...
10-05
温湿度不稳定、管理不当、授粉不良、坐果过多等原因会导致甜瓜化瓜。温湿度不稳定:田间的温度变化较大,或湿度不适,影响到花粉发育。连续遇到低温阴雨天气,阻碍了植株的光合作用,因此发生化瓜情况。管理不当:未...
09-09
鱼饵搅拌不均匀、饵水比不合适、开饵手法有问题、鱼饵装钩有问题等均可能导致鱼饵入水散落太快。鱼饵搅拌不均匀:开饵前将所有鱼饵混合在一起,并充分搅拌均匀。饵水比不合适:精准把控好兑水量,最好是使用量杯加水...
05-26
树体特征:幼茎具暗红色纵条纹,密被绒毛。幼叶绿色,叶缘有暗红晕,叶面和叶背均具密绒毛。成龄叶近圆形、中大、绿色,叶缘上卷,全缘或3裂,叶面无毛,叶背具稀疏绒毛,叶缘锯齿大,叶柄紫红色。一年生成熟枝条深...
08-06
气候变化、过度饮食、缺乏娱乐活动、胃肠炎等均可能导致猫咪精神萎靡、喜卧。气候变化:冬季气温较低,猫咪精神萎靡且嗜睡,但是进食及排尿正常,无需治疗。过度饮食:一般不需要用药,只需控制好猫咪每日的摄食量即...
05-23
黑玛丽鱼不是卵生或胎生动物,而是卵胎生。繁殖期间,雄性玛丽鱼会将生殖器放在雌性玛丽鱼的泄殖孔中,并排出精子,对鱼卵完成体内授精。受精卵会在雌鱼体内发育,成熟后便会被产出来。一、黑玛丽鱼属于卵生还是胎生...
12-14
柑橘的晚熟品种包括杂柑、夏橙、夏金、风晚、8号血橙等,这些品种的上市时间多为每年1月份下旬至6月份中旬。柑橘喜光耐阴,喜温耐寒,对土壤没有严格的要求,但更适合将它种植在肥沃疏松、具有较强排水性、呈微酸...
06-14
外观目测法:种胚凸出或皱缩、显黑暗无光泽的种子,其活性较强。浸种催芽法:种子浸泡后用湿润纸巾覆盖。并置于10-20℃环境中催芽,然后计算发芽率。红墨水染色法:配制红墨水溶液并将玉米种子放入其中浸泡,然...
08-22
禽类有家禽和飞禽两大类,其中家禽是指人工豢养的鸟类动物,飞禽则主要指善于飞行的野生鸟类。家禽是通常为雉科和鸭科动物,如鸡、鸭、鹅等,也有如火鸡、鹌鹑等其他科的鸟类。飞禽也有非常多的种类,如鹰、孔雀、白...
02-22
热点文章
冬季河蟹病害防治技术,需提供富含营养的饲料、营造适宜的蜕壳环境
先玉738玉米栽培技术要点,夏播生育期101天
黔丰优900水稻栽培技术要点,每亩有效穗数18.5万穗
全两优华占水稻栽培技术要点,秧田亩播种量8~10公斤
海桐是什么植物,对光照的需求比较高
九农Y2号大豆栽培技术要点,出苗至成熟平均126天
玺优447水稻栽培技术要点,6月20日前播种
中麦6032小麦栽培技术要点,为中强筋品种